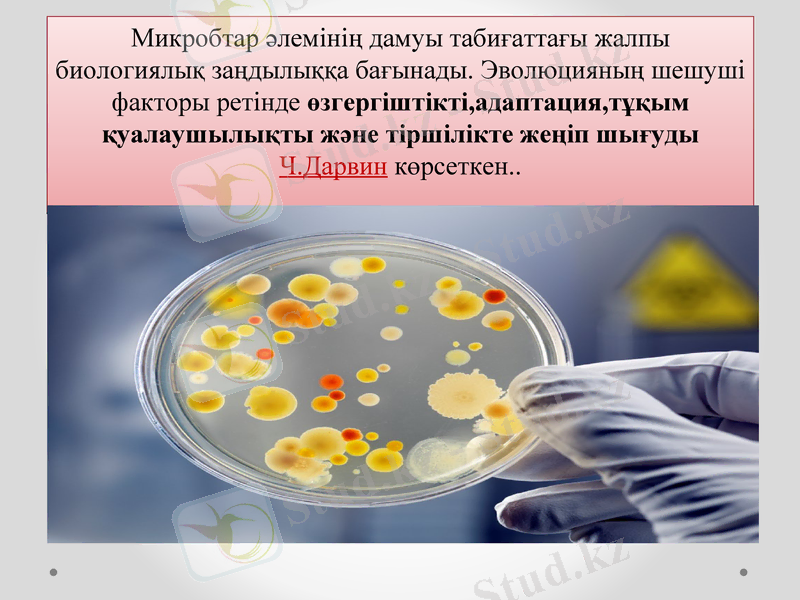
Slide 4

Микроорганизмдердің генетикалық өзгергіштігі: мутациялар мен плазмидтер



Қазақстан Республикасының ауыл-шаруашылылық министрлігі Қазақ ұлттық аграрлық университеті
Тақырыбы: Микробтардың генетикалық өзгергіштігі
Орындаған: Жұбан Гүлбаршын
Жумабергенова Ақтолқын
Қабылдаған: Уразбекова Гульжан

Жоспар I. Кіріспе II. Негізгі бөлім 2. 1. Микроорганизмдер генетикасы туралы жалпы түсінік 2. 2. Мутация процесі 2. 3. Мутация түрлері 2. 4. Плазмидтер III. Қорытынды

Микроорганизмдердің генетикасы тұқымқуалаушылық және өзгергіштік ілімі ретінде құрылысы мен биология сына сәйкес өзіне тән ерекшеліктері бар. Бактериялардың генетикасы көбірек зерттелген, олардың ерекшелік сипоты бактериалды жасушаның ұсақ өлшемі және көбеюінің жоғары жылдамдығы, мұның нәтижесі популяцияның үлкен санында қысқа уақыт аралығында генетикалық өзгерістерді анықтауға мүмкіндік береді.
Микробтар әлемінің дамуы табиғаттағы жалпы биологиялық заңдылыққа бағынады. Эволюцияның шешуші факторы ретінде өзгергіштікті, адаптация, тұқым қуалаушылықты және тіршілікте жеңіп шығуды Ч. Дарвин көрсеткен. .

Қандай организмді алсақ та ол өзінің ата тегіне ұқсас болады. Арнаулы құрылымдық және атқаратын қызметі жағынан белгілі бір қасиеттің біршама тұрақты күйде сақталып, ұрпақтан ұрпаққа беріліп отыруын тұқым қуалаушылық деп атаймыз. Сондай ақ әрбір жеке организмнің ата анасынан өзіндік ерекшеліктері болады. Бұл құбылысты өзгергіштік деп атайды.

Мутация латынша өзгеріс деген сөз. Ол морфологиялық және биохимиялық қасиеттердің өзгеруінен зат алмасудың тиімді бөлімінің қайтадан құрылуына алып келеді. Бұл қасиеттердің өзгерісі әр түрлі жағдайлардан: сәуле энергиясынан, түрлі химиялық әсерінен және басқа да факторлардың, яғни генетика тілімен айтқанда мутагендердің әсерінен болуы ықтимал.

Мутация түрі
Индукциялық
Спонтанды

Спонтандық немесе табиғи мутация- адамның қатысуынсыз табиғи мутагендік факторлардың әсерінен дамиды.
Индукциялық немесе жасанды мутациялар- белгілі мутагендік факторларды бағыталған әсерінендамиды (адамның қатысуымен)

Бактериялардың нуклеоидында ( "хромосома" ) шоғырланған гендердің жиынтығы генотип деп аталады.
Фенотип -генотиптің сыртқы ортамен өзара әрекеттесуі нәтижесінде пайда болған микроорганизмнің барлық белгілерінің жиынтығы.
Өз бетінше репликондармен көбейте алатын генетикалық элементтер = ДНҚ және плазмидтер.


екі тізбекті сақиналы молекула
молекулалық салмағы 1, 7 -2, 8 х109 дальтон
3 -5 х106 базалық жұпты қамтиды
гаплоидты Гендер жиынтығы бар
жасуша цитоплазмасында бірнеше рет бүктелген және тығыз оралған түрінде орналасқан
бактериялар үшін өмірлік маңызды белгілерді тудыратын гендер бар.
ДНҚ ("хромосома")

Бактериялардың модификациялары
Бактерияларындағы фенотиптік өзгерістер
ДНҚ-ның бастапқы құрылымының өзгеруімен қатар жүрмейді,
олар:
- микробтық жасушаның пішіні мен мөлшерінің өзгеруімен,
- колониялардың морфологиясымен,
- биохимиялық және антигендік белгілермен көрінеді.

ПЛАЗМИДТЕР
бактериялардағы экстрахромосомалық тұқым қуалаушылық факторлары
екі ішекті ДНҚ молекулалары
40 -50 генді алып жүреді
бактерия үшін өмірлік маңызды емес
тіршілік ету жағдайларына жақсы бейімделуге мүмкіндік беретін белгілерді анықтайды.
ықтимал күйлер автономды (цитоплазмада) біріктірілген (нуклеоидте) . Бұл жағдайда плазмид ЭПИСОМА деп аталады.

ПЛАЗМИДТЕР функциясы
реттеуші -нуклеоид ДНҚ функциясының бұзылуын өтейді, кодтау-генотипке жаңа ақпарат енгізеді.
кодтайтын нуклеоид-генотипке жаңа ақпарат енгізеді.

Қорытынды
Микроорганизмдер генетикасын зерттеу тек қана биологиялық маңызды емс, сонымен қатар көптеген медиицналық мәселелерді шешуге мүмкіндік береді. Микроорганизмдер генетикасы тұқымқуалаушылық және өзгергіштік ілімі ретінде құрылысы мен биология сына сәйкес өзіне тән ерекшеліктері бар. Хромосомаға ұқсас бактерияларды ң цитоплазмасында плазмида деп аталтынь ДНҚ-ның ковалентті тұйықталған сақинасы орналасады. Плазмид салмағы хромосома салмағынан аз. Хромосома мен плазмида автономдық өзінен көшіруге -репликацияға қабілетті, сондықтан оларды репликон дар деп атайды. Микроорганизмдердің қасиеті кез-келген басқа организмдер сияқты олардың генотипімен анықталлоды, яғни берілген дараның гендер жиынтығы. Бұл қасиеттерін зерттей келе микроорганизм тудырып тұрған аурудың түқым қуалаушылық қабілеттерін анықтауға болады.

БАҚЫЛАУ СҰРАҚТАРЫ
Эволюцияның шешуші факторы ретінде өзгергіштікті, адаптация т. б тіршілікте жеңіп шығуды көрсеткен кім?
Мутация неше түрге бөлінеді?
Бактерияларындағы фенотиптік өзгерістерін ата?

Пайдаланылған әдебиеттер
«Жалпы микробиология» Алматы, 2008 ж
Б. А. Рамазанованың және Қ. Құдайбердіұлының редакциялауымен шығарылған «Медициналық микробиология» Алматы, 2010 ж
Ү. Т. Арықбаева, К. Х. Алмағамбетов, Н. М. Бисенова, Ә. Ө. Байдүйсенова, Н. Б. Рахметова, Қ. Б. Қойшебаева, Н. В. Калина «Микробиология және Вирусология» Астана, 2006 ж
Стамкулова А. А., Қ. Құдайбергенұлы, Б. А. Рамазанов. -«Жалпы және жеке вирусология» Алматы 2010 ж.
Коротяев А. И, Бабичев С. Л. Медицинская микробиология, иммунология и вирусология. - СПб. : Спец. лит, с.

НАЗАР
АУДАРҒАНДАРЫҢЫЗҒА
РАХМЕТ
- Іс жүргізу
- Автоматтандыру, Техника
- Алғашқы әскери дайындық
- Астрономия
- Ауыл шаруашылығы
- Банк ісі
- Бизнесті бағалау
- Биология
- Бухгалтерлік іс
- Валеология
- Ветеринария
- География
- Геология, Геофизика, Геодезия
- Дін
- Ет, сүт, шарап өнімдері
- Жалпы тарих
- Жер кадастрі, Жылжымайтын мүлік
- Журналистика
- Информатика
- Кеден ісі
- Маркетинг
- Математика, Геометрия
- Медицина
- Мемлекеттік басқару
- Менеджмент
- Мұнай, Газ
- Мұрағат ісі
- Мәдениеттану
- ОБЖ (Основы безопасности жизнедеятельности)
- Педагогика
- Полиграфия
- Психология
- Салық
- Саясаттану
- Сақтандыру
- Сертификаттау, стандарттау
- Социология, Демография
- Спорт
- Статистика
- Тілтану, Филология
- Тарихи тұлғалар
- Тау-кен ісі
- Транспорт
- Туризм
- Физика
- Философия
- Халықаралық қатынастар
- Химия
- Экология, Қоршаған ортаны қорғау
- Экономика
- Экономикалық география
- Электротехника
- Қазақстан тарихы
- Қаржы
- Құрылыс
- Құқық, Криминалистика
- Әдебиет
- Өнер, музыка
- Өнеркәсіп, Өндіріс
Қазақ тілінде жазылған рефераттар, курстық жұмыстар, дипломдық жұмыстар бойынша біздің қор #1 болып табылады.



Ақпарат
Қосымша
Email: info@stud.kz